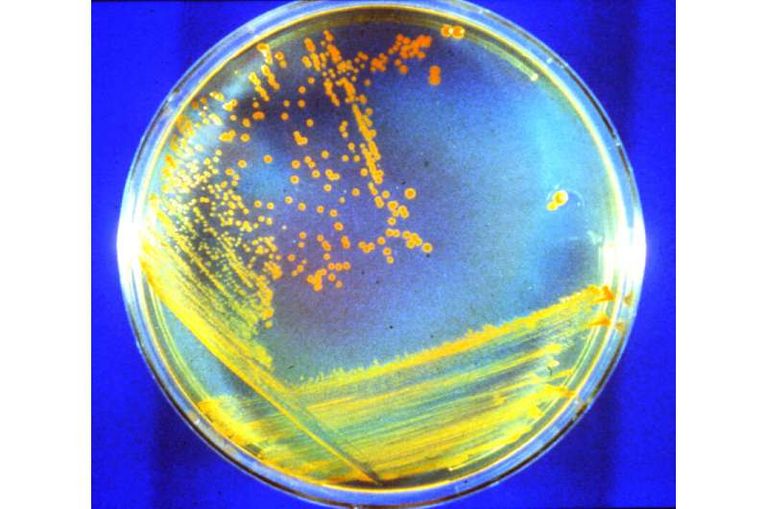
البكتيريا تم تعريضها لظروف المريخ لاختبار إمكانية بقائها

دراسة تكشف أسرار حياة البكتيريا على المريخ
في دراسة هي الأولى من نوعها، وجد فريق بحثي أن البكتيريا القديمة يمكن أن تعيش بالقرب من سطح المريخ لفترة أطول مما كان يُفترض سابقا.
ووفق الدراسة، عندما تُدفن البكتيريا تكون محمية من الإشعاع الكوني المجري والبروتونات الشمسية ويمكنها البقاء على قيد الحياة لفترة أطول، وهكذا، عندما تعود عينات المريخ الأولى إلى الأرض، يجب على العلماء أن يكونوا على اطلاع بالبكتيريا النائمة القديمة.
وتعزز هذه النتائج، المنشورة، الثلاثاء، في دورية "أستروبيولوجي"، احتمال أن تعود البعثات المستقبلية بما في ذلك "إكسو مارس" و"مستكشف حياة المريخ"، والتي ستحمل أدوات لاستخراج المواد من عمق مترين تحت السطح، بعينات بكتيرية.
ولأن العلماء أثبتوا أن سلالات معينة من البكتيريا يمكنها البقاء على قيد الحياة على الرغم من بيئة المريخ القاسية، يمكن لرواد الفضاء في المستقبل وسائحي الفضاء أن يلوثوا المريخ عن غير قصد ببكتيريا المشي لمسافات طويلة.
ويقول مايكل دالي، أستاذ علم الأمراض بجامعة نورث وسترن الأمريكية، وعضو لجنة الأكاديميات الوطنية لحماية الكواكب، التي قادت الدراسة: "الأهم من ذلك، أن هذه النتائج لها آثار دفاعية بيولوجية أيضًا، لأن تهديد العوامل البيولوجية مثل الجمرة الخبيثة لا يزال مصدر قلق للدفاع العسكري والداخلي".
ويضيف: "لقد توصلنا إلى أن التلوث الأرضي على سطح المريخ سيكون دائمًا على مدى آلاف السنين، قد يعقد هذا الجهود العلمية للبحث عن حياة المريخ، وبالمثل، إذا تطورت الميكروبات على المريخ، فيمكنها البقاء على قيد الحياة، وهذا يعني أن إعادة عينات المريخ يمكن أن تلوث الأرض".
والبيئة على كوكب المريخ قاسية ولا ترحم، وتجعل الظروف القاحلة والمتجمدة، والتي يبلغ متوسطها -80 درجة فهرنهايت (-63 درجة مئوية) عند خطوط العرض الوسطى، الكوكب الأحمر يبدو غير مضياف للحياة، والأسوأ من ذلك أن المريخ يتعرض أيضا للقصف المستمر من خلال الإشعاع الكوني المجري المكثف والبروتونات الشمسية.
ولاستكشاف ما إذا كانت الحياة ممكنة، حدد الباحثون أولاً حدود بقاء الإشعاع المؤين للحياة الميكروبية، وبعد ذلك، قاموا بتعريض ستة أنواع من البكتيريا والفطريات الأرضية لمحاكاة سطح المريخ - المجمد والجاف - وقاموا بتلويثها بأشعة جاما أو البروتونات (لتقليد الإشعاع في الفضاء).
ووجد الباحثون أن بعض الكائنات الحية الدقيقة الأرضية يمكن أن تعيش على المريخ على مدى فترات زمنية جيولوجية لمئات الملايين من السنين.
في الواقع، اكتشف الباحثون أن أحد الميكروبات القوية "مكورة غريبة مقاومة للإشعاع"، مناسبة بشكل خاص للبقاء على قيد الحياة في ظروف المريخ القاسية، وفي التجارب الجديدة، نجت البكتيريا من كميات فلكية من الإشعاع في البيئة القاحلة المتجمدة\.
ولاختبار تأثيرات الإشعاع، عرّض الفريق البحثي عينات لجرعات كبيرة من إشعاع جاما والبروتونات، وهي جرعات نموذجية لما يتلقاه المريخ في ما تحت السطح القريب، وجرعات أصغر بكثير، والتي يمكن أن تحدث إذا تم دفن كائن حي دقيق بعمق.
وبعد ذلك، استخدم فريق هوفمان في نورث وسترن تقنية التحليل الطيفي المتقدمة لقياس تراكم مضادات الأكسدة المنجنيز في خلايا الكائنات الحية الدقيقة المشعة.
ووفقًا لهوفمان، فإن حجم جرعة الإشعاع التي يمكن أن تحياها الكائنات الحية الدقيقة أو جراثيمها يرتبط بكمية مضادات الأكسدة التي تحتوي عليها المنجنيز، لذلك، فإن المزيد من مضادات الأكسدة من المنجنيز تعني مقاومة أكبر للإشعاع والمزيد من البقاء على قيد الحياة.
وفي دراسات سابقة وجد باحثون سابقون أن بكتيريا "مكورة غريبة مقاومة للإشعاع "، عند تعليقها في سائل، يمكنها البقاء على قيد الحياة 25000 وحدة من الإشعاع، أي ما يعادل حوالي 1.2 مليون سنة تحت سطح المريخ.
aXA6IDIxNi43My4yMTYuMTYxIA== جزيرة ام اند امز